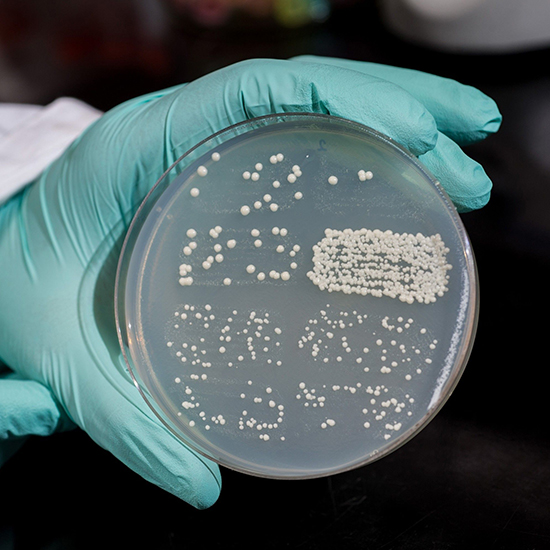

Молекулярные методы мониторинга физиологии бактерий
Пептидогликаны являются важными компонентами клеточной стенки, определяющими морфологическую стабильность и жизнеспособность большинства бактерий. Биосинтез пептидогликанов включает каскад реакций периплазматической транспептидации, посредством чего происходит формирование поперечных пептидных связей между полисахаридными цепями для придания им механической прочности. Однако отслеживание реакций транспептидации in vivo и in vitro представляет сложную задачу, главным образом из-за отсутствия эффективных биосовместимых зондов.
Пептидогликаны являются важными компонентами клеточной стенки, определяющими морфологическую стабильность и жизнеспособность большинства бактерий. Биосинтез пептидогликанов включает каскад реакций периплазматической транспептидации, посредством чего происходит формирование поперечных пептидных связей между полисахаридными цепями для придания им механической прочности. Однако отслеживание реакций транспептидации in vivo и in vitro представляет сложную задачу, главным образом из-за отсутствия эффективных биосовместимых зондов.
В работе, представленной в издании «Nature Chemistry» 25 февраля 2019 г., научные сотрудники кафедры молекулярной и клеточной биохимии Индианского университета в Блумингтоне (Indiana University, Bloomington), США, сообщили о разработке, синтезе и потенциале применения ротор-флуорогенных D-аминокислот (rotor-fluorogenic D-amino acids — RfDAA), позволяющих в режиме реального времени непрерывно отслеживать реакции транспептидации. Такие молекулярные зонды позволяют осуществлять мониторинг биосинтеза пептидогликанов в режиме реального времени путем визуализации транспептидазных реакций в живых клетках, а также анализа активности D,D- и L,D-транспептидаз и сортаз in vitro. По словам авторов работы, уникальная способность RfDAA флуоресцировать при включении в структуру пептидогликана обеспечивает новый мощный инструмент для изучения биосинтеза клеточного каркаса, обладая высоким временным разрешением и возможностью высокоточного скрининга ингибиторов биосинтеза пептидогликана. Углубленное понимание механизмов построения клеточной стенки бактериями могло бы расширить перспективы поиска новых препаратов антибактериального спектра действия.
Пути преодоления антибиотикорезистентности
Антибиотикорезистентность является актуальным вопросом общественного здравоохранения, представляя собой серьезную и неотложную угрозу здоровью. По данным Центров по контролю и профилактике заболеваний, по меньшей мере, у 2 млн человек в США ежегодно регистрируются случаи устойчивых к антибактериальной терапии инфекционных заболеваний, по причине которых около 23 тыс. человек умирают. Подобная ситуация определяет непреходящую значимость поиска новых препаратов, которые бы позволяли повысить эффективность антибактериальной терапии.
Более ранними исследованиями были представлены разработки двух клеточных зондов на основе флуоресцентных D-аминокислот (fluorescent D-amino acids — FDAA) и дипептидов D-аминокислот (D-amino acid dipeptides — DAAD), которые в настоящее время нашли применение в исследовательских диагностических лабораториях по всему миру. Новый класс молекулярных зондов, представленный в настоящем исследовании, сочетает в себе основы ранних разработок и назван ротор-флуорогенными D-аминокислотами, или RfDAA. Комментируя этот инструмент молекулярной диагностики, авторы работы указали на то, что в новой технологии использованы преимущества определенных клеточных ферментов для прикрепления цветных красителей, или «зондов», к стенкам бактериальных клеток. Поскольку же эти ферменты ингибируются другими хорошо известными антибактериальными соединениями, прежде всего пенициллином, ученые выдвинули гипотезу о возможности применения таких молекулярных зондов для поиска абсолютно новых классов лекарственных средств, ингибирующих эти ферментативные процессы.
Основным преимуществом молекулярных зондов RfDAA является простота их применения и способность визуализировать клеточную активность в режиме реального времени. Это связано с тем, что зонды не требуют этапов промывки для удаления неинкорпорированных химических соединений, нивелирующих четкость границ между бактериальными клетками и межклеточным пространством. В противоположность этому RfDAA начинают флуоресцировать с момента интеграции их в бактериальные клеточные стенки, отражая этап естественного процесса роста. Таким образом, зонды RfDAA позволяют визуализировать клеточные стенки быстрее и четче, исключая этапы, которые потенциально могли бы приостанавливать клеточную активность.
Перспективы применения в клинических исследованиях
В заключение, отмечая перспективность дальнейшего практического применения новой молекулярной разработки, авторы сообщили о начале сотрудничества с Медицинской школой Индианского университета в Блумингтоне. Результаты совместных биомедицинских исследований могли бы стать основой применения молекулярных аминокислотных зондов для поиска новых ингибиторов синтеза бактериальной клеточной стенки. Кроме того, подобные зонды могли бы использоваться для изучения процессов деления и роста бактериальных клеток, что могло бы расширить диапазон целей в разработке альтернативных антибактериальных препаратов.
Подписывайтесь на наш Telegram-канал, Viber-сообщество, Instagram, страничку Facebook, а также Twitter, чтобы первыми получать самые свежие и актуальные новости из мира медицины.
- Hsu Y.-P., Hall E., Booher G. et al. (2019) Fluorogenic d-amino acids enable real-time monitoring of peptidoglycan biosynthesis and high-throughput transpeptidation assays. Nat. Chem., Feb. 25. DOI: 10.1038/s41557-019-0217-x [Epub. ahead of print].
- Indiana University (2019) New chemical probes advance search for new antibiotics. ScienceDaily, Mar. 1.
Наталья Савельева-Кулик





